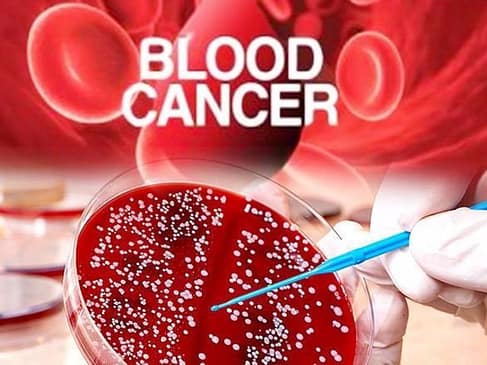
Blood Cancer

Cancer की शुरुआत कैसे होती है और उसके लक्षण क्या है
आज हम जानेंगे Cancer क्या है मानव शरीर में जब कोशिकाओं के जीन में बदलाव होने लगता है, तब कैंसर की शुरुआत होने लगती है।
Cancer क्या है ?
जानिए Cancer क्या है। कैंसर’ का नाम सुनते ही दिमाग में डर का माहौल बन जाता है।
हमारे शरीर में कोशिकाओं (सेल्स) का लगातार विभाजन होता रहता है और यह एक सामान्यसी प्रक्रिया है,
जिस पर शरीर का पूरा कंट्रोल रहता है।
लेकिन जब शरीर के किसी खास अंग की कोशिकाओं पर शरीर का कंट्रोल नहीं रहता
और वे असामान्य रूप से बढ़ने लगता हैं तो उसे कैंसर कहा जाता हैं।
अगर जानकारी और सही उपचार हो इसे पूरी तरह कंट्रोल किया जा सकता है।
जाने कैंसर की शुरूआत कैसे होती है ?
जानिए Cancer क्या है और लक्षण
मानव शरीर में जब कोशिकाओं के जीन में बदलाव होने लगता है,
तब कैंसर की शुरुआत होने लगती है ।
ऐसा नहीं है कि किसी विशेष कारण से ही जीन में बदलाव होते हैं, यह स्वंय भी बदल सकते हैं
या फिर दूसरे कारणों की वजह से ऐसा हो सकता है, जैसे-
गुटका-तंबाकू
जैसी नशीली चीजें खाने से, अल्ट्रावॉलेट रे या फिर रेडिएशन आदि इसके लिए जिम्मेदार हो सकते हैं ।
ज्यादातर यह देखा गया है कि कैंसर शरीर में रोग प्रतिरोधक क्षमता यानि इम्यून सिस्टम की कोशिकाओं को समाप्त कर देता है,
परंतु कभी-कभी कैंसर की कोशिकाएं को इम्यून सिस्टम झेल नहीं पाता और व्यक्ति को कैंसरजैसी लाइलाज बिमारी हो जाती है ।
जैसे-जैसे शरीर में कैंसर वाली कोशिकाएं बढ़ने लगती हैं,
वैसे-वैसे ट्यूमर यानि एक प्रकार की गांठ बढ़ती रहती है।
इसका उपचारसही समय पर न किया जाए तो यह पूरे शरीर में फैल जाता है।
कैंसर के प्रकार कितने होते है?
डॉक्टर्स और शोधकर्ता मानते हैं कि कैंसर 200 से भी अधिक तरह का होता है
और इसीलिए इनके लक्षण भी विभिन्न होते हैं।
लेकिन इस लेख में सिर्फ उन्हीं कैंसर के बारे में बताएंगेजिन्होंने लोगों को बहुत तेजी से अपना शिकार बनाया है ।
चलिए जानते हैं कि वो कैंसर के कौन से प्रकार हैं –
ब्लड कैंसर –
लोगों में सबसे तेजी से बढ़ने वाले कैंसर में ब्लड कैंसर सबसे आगे है।
इस कैंसर में व्यक्ति के शरीर की रक्त कोशिकाओं में कैंसर पैदा होने लगता है
लाल रक्त कोशिका का उत्पादन करना बंद कर देता है।
और इसी के चलते शरीर में रक्त की कमी हो जाती है
और कैंसर बहुत तेजी से शरीर में संक्रमित होना शुरू हो जाता है।
फेफड़ों का कैंसर –
फेफड़ों के कैंसर में व्यक्ति की स्थिति बहुत दयनीय और खराब हो जाती है।
सांस लेने में परेशानी, बलगम जमने की दिक्कत, हड्डियों-जोड़ों में बेहिसाब दर्द और भूख ना लगना।
जो किसी व्यक्ति की सांस लेने की क्षमता को कम करता है। इसके प्रमुख लक्षण हैं ।
शरीर में भारी कमजोरी का आभास होता है । हर समय बेवजह ही थकान लगी रहती है ।
फेफड़ों के कैंसर के बढ़ने की वजह धुम्रपान भी एक बड़ा कारण है।
ब्रेन कैंसर –
ब्रेन कैंसर व्यक्ति के सिर वाले भाग में होता है । ब्रेन कैंसर का दूसरा नाम है ब्रेन ट्यूमर ।
इस कैंसर वाले रोगी के दिमाग वाले भाग में एक ट्यूमर यानि गांठ बन जाती है
और यह गांठ समय के साथ-साथ बड़ी होने लगती है और धीरे-धीरे पूरे मस्तिष्क में फैल जाती है ।
इससे मनुष्यको बहोत तकलीफ उठानी पड़ती है।
स्तन कैंसर –
स्तन कैंसर या जिसे ब्रैस्ट कैंसर भी कहते हैं, यह विशेषकर महिलाओं को होता है.
परंतु ऐसा नहीं है कि यह पुरुषों को नहीं हो सकता ।
इस कैंसर से ग्रसित औरतों के स्तन में एक प्रकार की गांठ बननी शुरु हो जाती है,
जो धीरे-धीरे समयानुसार बढ़ने लगती है ।
यदि इससे बचाव करना है तो नियमित रूप से स्तन की जांच करवाते रहें।
चर्म यानि स्किन कैंसर-
चर्म कैंसर यानि स्किन कैंसर के मामले भी देश में बहुत तेजी से सामने आ रहे हैं.
एक्जिमा होना-
एक्जिमा यानी खाज होना ये भी स्किन कैंसर का लक्षण हो सकता है।
खासतौर पर अगर यह समस्या कोहनी, हथेली या घुटनों पर दिखे तो इसे लेकर लापरवाही न करते तुरंत डॉक्टर से सलाह लें।
डॉक्टर्स का कहना है कि स्किन कैंसर बहुत अधिक गर्मी में रहने वाले , उचित भोजन न करने और शून्य शारीरिक गतिविधि न करने से शरीर में होता है ।
स्किन कैंसर हर उम्र के व्यक्ति को हो सकता है ।
Conclusion –
आज हमने Cancer के बारे में जान लिया उसके लक्षण क्या है कोनसे कोनसे प्रकार है इसकी जानकारी दी है।हमने सभी चीजे आपको details से बताने की कोशिश की गयी है. फिर भी कुछ समाज ना आया हो तो आप हमें comment के जरिये सूचित कर सकते है. और हम रोज ऐसी ही नयी नयी जानकारी share करते रहते है। अगर आज की यह पोस्ट अछि लगी हो तो इसे जरूर शेयर करे। धन्यवाद्।
Visit my Site – Healthcaregyan